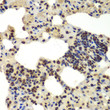
Immunohistochemistry analysis of paraffin-embedded rat lung using DDX5 antibody (STJ115258) at dilution of 1:100 (40x lens). Perform microwave antigen retrieval with 10 mM PBS buffer pH 7. 2 before commencing with immunohistochemistry staining protocol.

Anti-DDX5 antibody (1-614) (STJ115258)
SPECIFICATIONS
ClonalityPolyclonal
HostRabbit
ConjugationUnconjugated
IsotypeIgG
General Information
| Short Description | Rabbit polyclonal DDX5 (1-614) antibody for use in WB, IHC-P and ELISA in human, mouse and rat samples. Datasheet included with dilution recommendations, and related reagents. |
| Applications | WB/IHC-P/ELISA |
| Host | Rabbit |
| Reactivity | Human/Mouse/Rat |
| Note | STRICTLY FOR FURTHER SCIENTIFIC RESEARCH USE ONLY (RUO). MUST NOT TO BE USED IN DIAGNOSTIC OR THERAPEUTIC APPLICATIONS. |
Product Properties
| Clonality | Polyclonal |
| Isotype | IgG |
| Conjugation | Unconjugated |
| Concentration | Lot specific |
| Purification | Affinity purification |
| Dilution Range | WB:1:500-1:2000IHC-P:1:50-1:200ELISA:Recommended starting concentration is 1 Mu g/mL. Please optimize the concentration based on your specific assay requirements. |
| Formulation | PBS with 0.02% Sodium Azide, 50% Glycerol, pH 7.3. |
| Storage Instruction | Store at-20°C for up to 1 year from the date of receipt, and avoid repeat freeze-thaw cycles. |
Target Information
| Gene Symbol | DDX5 |
| Gene ID | 1655 |
| Uniprot ID | DDX5_HUMAN |
| Immunogen Region | 1-614 |
| Immunogen Sequence | MSGYSSDRDRGRDRGFGAPR FGGSRAGPLSGKKFGNPGEK LVKKKWNLDELPKFEKNFYQ EHPDLARRTAQEVETYRRSK EITVRGHNCPKPVLNFYEAN FPANVMDVIARQNFTEPTAI QAQGWPVALSGLDMVGVAQT GSGKTLSYLLPAIVHINHQP FLERGDGPICLVLAPTRELA QQVQQVAAEYCRACRLKSTC IYGGAPKGPQIRDLERGVEI CIATPGRLIDFLECGKTNL |
| Specificity | Recombinant fusion protein containing a sequence corresponding to amino acids 1-614 of human DDX5 (NP_004387.1). |
Additional Info
| Post Translational Modifications | Arg-502 is dimethylated, probably to asymmetric dimethylarginine. Sumoylated.sumoylation, promoted by PIAS1, promotes interaction with HDAC1 and transcriptional repression activity. Sumoylation also significantly increases stability, and reduces polyubiquitination. Polyubiquitinated, leading to proteasomal degradation. Weakly phosphorylated in the G1/S phase of the cell cycle and much more at G2/M, especially at Thr and Tyr residues. |
| Function | Involved in the alternative regulation of pre-mRNA splicing.its RNA helicase activity is necessary for increasing tau exon 10 inclusion and occurs in a RBM4-dependent manner. Binds to the tau pre-mRNA in the stem-loop region downstream of exon 10. The rate of ATP hydrolysis is highly stimulated by single-stranded RNA. Involved in transcriptional regulation.the function is independent of the RNA helicase activity. Transcriptional coactivator for androgen receptor AR but probably not ESR1. Synergizes with DDX17 and SRA1 RNA to activate MYOD1 transcriptional activity and involved in skeletal muscle differentiation. Transcriptional coactivator for p53/TP53 and involved in p53/TP53 transcriptional response to DNA damage and p53/TP53-dependent apoptosis. Transcriptional coactivator for RUNX2 and involved in regulation of osteoblast differentiation. Acts as a transcriptional repressor in a promoter-specific manner.the function probably involves association with histone deacetylases, such as HDAC1. As component of a large PER complex is involved in the inhibition of 3' transcriptional termination of circadian target genes such as PER1 and NR1D1 and the control of the circadian rhythms. |
| Protein Name | Probable Atp-Dependent Rna Helicase Ddx5Dead Box Protein 5Rna Helicase P68 |
| Database Links | Reactome: R-HSA-3899300Reactome: R-HSA-72163Reactome: R-HSA-9018519Reactome: R-HSA-9682706Reactome: R-HSA-9694686 |
| Cellular Localisation | NucleusNucleolusNucleus SpeckleCytoplasmDuring The G0 PhasePredominantly Located In The NucleusCytoplasmic Levels Increase During The G1/S PhaseDuring The M PhaseLocated At The Vicinity Of The Condensed ChromosomesAt G1Localizes In The Cytoplasm |
| Alternative Antibody Names | Anti-Probable Atp-Dependent Rna Helicase Ddx5 antibodyAnti-Dead Box Protein 5 antibodyAnti-Rna Helicase P68 antibodyAnti-DDX5 antibodyAnti-G17P1 antibodyAnti-HELR antibodyAnti-HLR1 antibody |
Information sourced from Uniprot.org